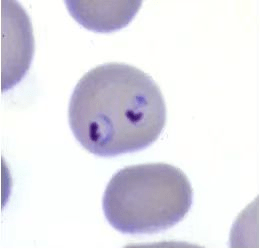

五一马上到了!出国游玩要小心,谨防被“疟”!
马上就到五一小长假了,今年的节假日像在报复性消费一样,刷朋友圈就像是在看低配版的“《舌尖上的世界》+《世界地理》”,出国浪的人也不在少数,但小编提醒一句,小心受“疟”!

2023年4月26日,是我国第16个“全国疟疾日”,今年的主题是“谨防输入性疟疾,持续巩固消除成果”。


全国疟疾日national malaria day
疟疾在我国流行历史非常久远,早在三千年前即有疟疾记载。新中国成立前疟疾广泛分布于我国,20世纪40年代每年报告约3000万疟疾病例,疟疾严重危害着人民健康。2017年,我国首次实现0本土病例报告的重大突破,至今已连续5年无本地原发感染疟疾病例报告。2021年6月30日,WHO宣布中国成为第40个消除疟疾的国家。虽然我国成功消除了疟疾,但是每年仍有2000多例输入性疟疾,境外输入疟疾引起再传播风险持续存在。因此我们也不能掉以轻心,大家赶紧一起来学习疟疾的有关知识吧!
一、什么是疟疾?
疟疾又叫“打摆子”、“冷热病”,是由疟原虫引起的寄生虫病。据WHO数据统计,2021年,全球约报告2.47亿疟疾病例和61.9万例疟疾相关死亡病例。引起疟疾的疟原虫主要有恶性疟、间日疟、三日疟和卵形疟4种。
恶性疟原虫环状体
恶性疟原虫环状体
 间日疟原虫环状体
间日疟原虫环状体
 三日疟原虫环状体
三日疟原虫环状体
 卵形疟原虫环状体
卵形疟原虫环状体
二、得了疟疾有什么症状?
当被疟原虫寄生的红细胞成批地破裂,释放出疟原虫裂殖子及其代谢产物时,就会刺激机体产生强烈的免疫反应。
- 发作前:
- 有疲乏、头痛、畏寒、低热等症状。
- 发作时:
- 经历寒战、发热、出汗的周期性症状。

发作多次后可出现脾大、贫血等。如不及时救治,有可能因病情延误而危及生命。
三、疟疾是怎样传播的?
疟疾的传染源是现症病人或无症状感染者,当其末梢血中存在配子体时具有传染性。疟疾的传播媒介是按蚊。按蚊叮刺吸入患者或感染者的血后,再叮刺吸入正常人的血时,就将疟原虫传给后者。

另外,还可因胎盘受损或在分娩过程中,患疟疾或带疟原虫的母体的血污染胎儿伤口,由母体传给胎儿,造成先天性疟疾;也可经输血传播。

四、哪些地方是流行区
疟疾目前主要在非洲、美洲、亚洲的热带和亚热带等地区流行。流行区的患者或感染者进入非流行区时可传播疟疾。因此,需防范人口跨境流动造成的疟疾传播风险。
五、如何预防疟疾?
我国为非疟疾流行区,出国时需关注目的地是否为疟疾流行区,做好个人防护。疟疾主要通过蚊子传播,因此防蚊虫叮咬最重要。预防蚊子叮咬。具体要做到以下几点:
01外出时穿浅色长衣长裤
外出要穿浅色的长袖衣服及长裤,蚊子喜欢停在深色衣服上。

02使用蚊虫驱避药物
外露皮肤及衣服上喷、涂抹含有避蚊胺成分的蚊虫驱避药物。

03勤洗澡,勤换衣物,保持干净
蚊子喜欢叮出汗多、味道重的人,勤洗澡,勤换衣物,可以去除身上分泌的汗水味道,减少蚊子的袭击。

04不去阴暗潮湿地
避免在蚊虫出没频繁的时段在树荫、草丛、凉亭等户外阴暗潮湿处逗留。

05要做好个人健康监测
回国后,要做好个人健康监测,一旦出现发热、发冷、大量出汗等症状,要及时就医,并主动告知医生发病前的旅居史。
由于疟疾传播媒介和流行条件尚未得到根本性改变,输入性疟疾再传播风险仍然持续存在。全球特别是非洲和东南亚等地区疟疾流行依然十分严重。对假期有计划出入境的重点人群发出健康提示:应当做好个人防护,增强主动就诊、及时治疗的意识。同时增强一线医务人员疟疾诊治意识和能力,从源头上减少疟疾感染、传播和危重风险,持续巩固我国消除疟疾成果。
来源:东莞疾控

